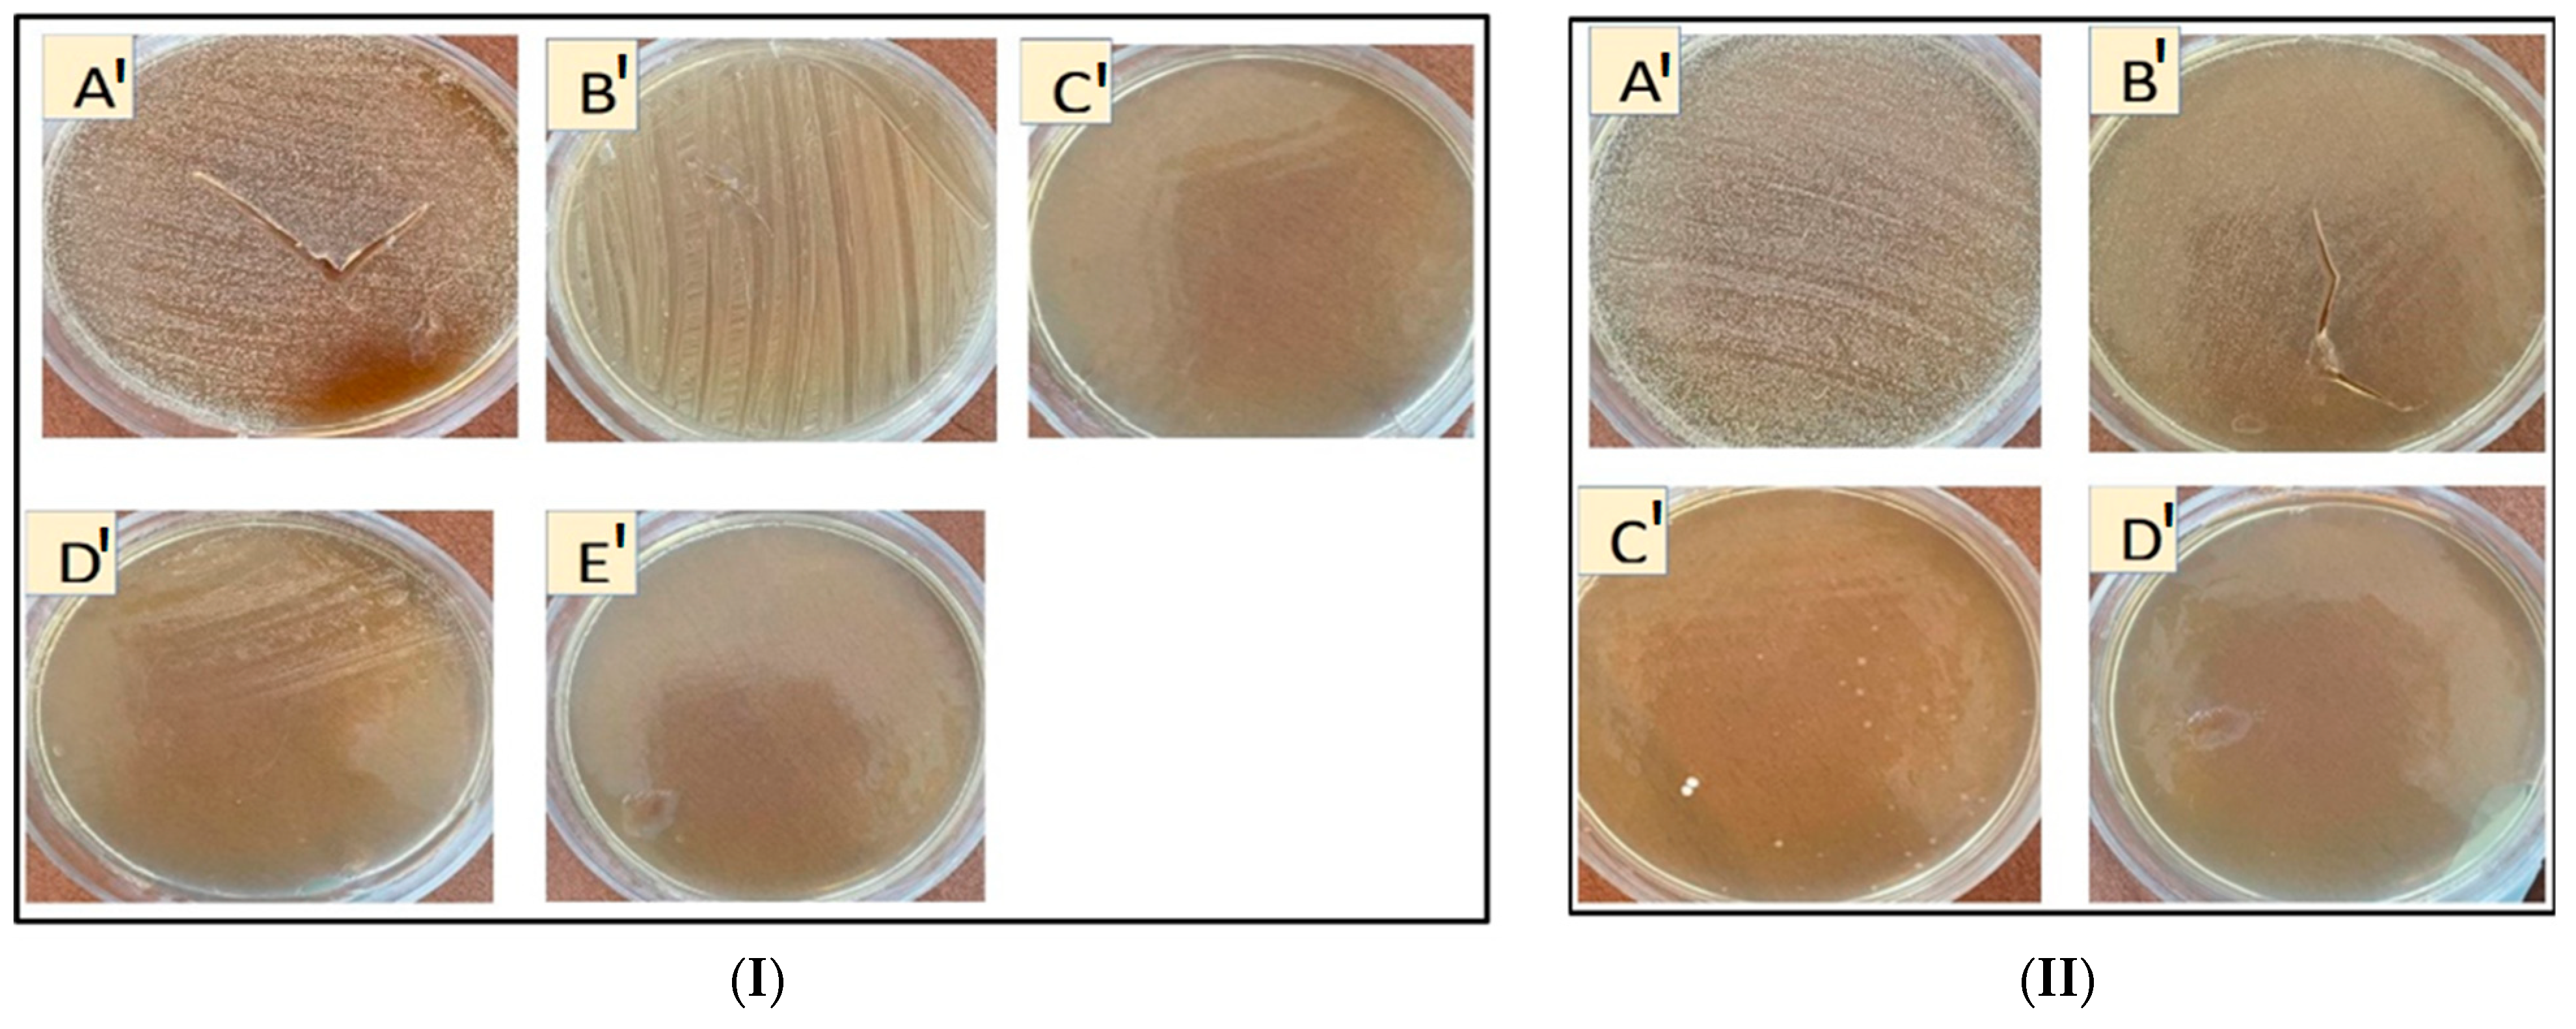
Pharmaceutics 14 00685 g005

Cyclodextrin-Based Nanosponges as Perse Antimicrobial Agents Increase the Activity of Natural Antimicrobial Peptide Nisin
Abstract
:1. Introduction
- The enhancement of the antibacterial effect of nisin Z complexed with CD-based NSs and β-CD;
- The understanding of the antibacterial activity of CD-NSs and β-CD;
- The evaluation of the influence of CD-NSs and β-CD for enhancing the conservative effect of nisin Z on cooked chicken meat and preventing the decomposition of nisin in present pepsin.
2. Materials and Methods
2.1. Materials
2.2. Methods
2.2.1. Synthesis of β-Cyclodextrin-Based Nanosponges
2.2.2. Preparation of Nisin-Z-Loaded β-CD-Based NSs
2.2.3. Fourier Transformed Infrared Study
2.2.4. In Vitro Release Study
2.3. Antimicrobial Activity Assays
2.3.1. Preparation of Bacterial Strains, Medium, and Cultivation
2.3.2. Antimicrobial Evaluation in Solid Culture Medium
2.3.3. Antimicrobial Evaluation in Liquid Culture Medium
2.3.4. Capacity of Bacteria to Use β-CD and NSs as Carbon Sources
2.3.5. Total Viable Counts (TVCs)
2.4. Statistical Analysis
3. Results and Discussion
3.1. Characterization and In Vitro Release
3.2. Antimicrobial Activity Assays
3.2.1. Inhibition Zone Diameter
3.2.2. Inhibition of Bacteria Growth Rate in BHI
3.2.3. MIC and MBC
3.2.4. Capacity of Bacteria to Use β-CD and Nanosponges as Carbon Sources
3.2.5. Total Viable Counts (TVCs)
4. Conclusions
Supplementary Materials
Author Contributions
Funding
Institutional Review Board Statement
Informed Consent Statement
Data Availability Statement
Acknowledgments
Conflicts of Interest
References
- BBonev, B.B.; Brown, N.M. Bacterial Resistance to Antibiotics: From Molecules to Man; John Wiley & Sons: Hoboken, NJ, USA, 2019. [Google Scholar]
- O’Neill, J. Tackling Drug-Resistant Infections Globally: Final Report and Recommendations; APO: Leipzig, Germany, 2016. [Google Scholar]
- Abraham, E.P.; Chain, E. An enzyme from bacteria able to destroy penicillin. Nature 1940, 146, 837. [Google Scholar] [CrossRef]
- Blair, J.M.; Webber, M.A.; Baylay, A.J.; Ogbolu, D.O.; Piddock, L.J. Molecular mechanisms of antibiotic resistance. Nat. Rev. Microbiol. 2015, 13, 42–51. [Google Scholar] [CrossRef] [PubMed]
- Ramu, R.; Shirahatti, P.S.; Devi, A.T.; Prasad, A. Bacteriocins and their applications in food preservation. Crit. Rev. Food Sci. Nutr. 2017, 60, II. [Google Scholar] [CrossRef]
- Gharsallaoui, A.; Oulahal, N.; Joly, C.; Degraeve, P. Nisin as a food preservative: Part 1: Physicochemical properties, antimicrobial activity, and main uses. Crit. Rev. Food Sci. Nutr. 2016, 56, 1262–1274. [Google Scholar] [CrossRef] [PubMed]
- Ross, R.P.; Morgan, S.; Hill, C. Preservation and fermentation: Past, present and future. Int. J. Food Microbiol. 2002, 79, 3–16. [Google Scholar] [CrossRef] [Green Version]
- Meyer, J.E.; Harder, J. Antimicrobial peptides in oral cancer. Curr. Pharm. Des. 2007, 13, 3119–3130. [Google Scholar] [CrossRef]
- Yang, S.-C.; Lin, C.-H.; Sung, C.T.; Fang, J.-Y. Antibacterial activities of bacteriocins: Application in foods and pharmaceuticals. Front. Microbiol. 2014, 5, 241. [Google Scholar]
- Zhang, N.; Li, J.; Jiang, W.; Ren, C.; Li, J.; Xin, J.; Li, K. Effective protection and controlled release of insulin by cationic β-cyclodextrin polymers from alginate/chitosan nanoparticles. Int. J. Pharm. 2010, 393, 213–219. [Google Scholar] [CrossRef]
- Alves, F.C.; Barbosa, L.N.; Andrade, B.F.; Albano, M.; Furtado, F.B.; Pereira, A.F.M.; Rall, V.L.; Júnior, A.F. Inhibitory activities of the lantibiotic nisin combined with phenolic compounds against Staphylococcus aureus and Listeria monocytogenes in cow milk. J. Dairy Sci. 2016, 99, 1831–1836. [Google Scholar] [CrossRef] [Green Version]
- Biswaro, L.S.; da Costa Sousa, M.G.; Rezende, T.; Dias, S.C.; Franco, O.L. Antimicrobial peptides and nanotechnology, recent advances and challenges. Front. Microbiol. 2018, 9, 855. [Google Scholar] [CrossRef] [Green Version]
- Ghorbanzade, T.; Jafari, S.M.; Akhavan, S.; Hadavi, R. Nano-encapsulation of fish oil in nano-liposomes and its application in fortification of yogurt. Food Chem. 2017, 216, 146–152. [Google Scholar] [CrossRef] [PubMed]
- Jafari, S.M.; Assadpoor, E.; He, Y.; Bhandari, B. Encapsulation efficiency of food flavours and oils during spray drying. Dry. Technol. 2008, 26, 816–835. [Google Scholar] [CrossRef]
- Punyauppa-path, S.; Phumkhachorn, P.; Rattanachaikunsopon, P. Nisin: Production and mechanism of antimicrobial action. Int. J. Curr. Res. Rev. 2015, 7, 47. [Google Scholar]
- Siroli, L.; Camprini, L.; Pisano, M.B.; Patrignani, F.; Lanciotti, R. Volatile molecule profiles and anti-Listeria monocytogenes activity of nisin producers Lactococcus lactis strains in vegetable drinks. Front. Microbiol. 2019, 10, 563. [Google Scholar] [CrossRef]
- Kumar, S.; Trotta, F.; Rao, R. Encapsulation of babchi oil in cyclodextrin-based nanosponges: Physicochemical characterization, photodegradation, and in vitro cytotoxicity studies. Pharmaceutics 2018, 10, 169. [Google Scholar] [CrossRef] [Green Version]
- Tiwari, G.; Tiwari, R.; Rai, A.K. Cyclodextrins in delivery systems: Applications. J. Pharm. Bioallied Sci. 2010, 2, 72. [Google Scholar] [CrossRef]
- Krabicová, I.; Appleton, S.L.; Tannous, M.; Hoti, G.; Caldera, F.; Rubin Pedrazzo, A.; Cecone, C.; Cavalli, R.; Trotta, F. History of cyclodextrin nanosponges. Polymers 2020, 12, 1122. [Google Scholar] [CrossRef]
- Matencio, A.; Hoti, G.; Monfared, Y.K.; Rezayat, A.; Pedrazzo, A.R.; Caldera, F.; Trotta, F. Cyclodextrin Monomers and Polymers for Drug Activity Enhancement. Polymers 2021, 13, 1684. [Google Scholar] [CrossRef]
- Matencio, A.; Caldera, F.; Cecone, C.; López-Nicolás, J.M.; Trotta, F. Cyclic oligosaccharides as active drugs, an updated review. Pharmaceuticals 2020, 13, 281. [Google Scholar] [CrossRef]
- Matencio, A.; Dhakar, N.K.; Bessone, F.; Musso, G.; Cavalli, R.; Dianzani, C.; García-Carmona, F.; López-Nicolás, J.M.; Trotta, F. Study of oxyresveratrol complexes with insoluble cyclodextrin based nanosponges: Developing a novel way to obtain their complexation constants and application in an anticancer study. Carbohydr. Polym. 2020, 231, 115763. [Google Scholar] [CrossRef]
- Matencio, A.; Rubin Pedrazzo, A.; Difalco, A.; Navarro-Orcajada, S.; Khazeai Monfared, Y.; Conesa, I.; Rezayat, A.; López-Nicolás, J.M.; Trotta, F. Advances and Classification of Cyclodextrin-Based Polymers for Food-Related Issues. Polymers 2021, 13, 4226. [Google Scholar] [CrossRef] [PubMed]
- Lucia Appleton, S.; Navarro-Orcajada, S.; Martínez-Navarro, F.J.; Caldera, F.; López-Nicolás, J.M.; Trotta, F.; Matencio, A. Cyclodextrins as Anti-inflammatory Agents: Basis, Drugs and Perspectives. Biomolecules 2021, 11, 1384. [Google Scholar] [CrossRef] [PubMed]
- EFSA Panel on Dietetic Products, Nutrition and Allergies. Scientific Opinion on the substantiation of health claims related to alpha cyclodextrin and reduction of post prandial glycaemic responses (ID 2926, further assessment) pursuant to Article 13 (1) of Regulation (EC) No 1924/2006. EFSA J. 2012, 10, 2713. [Google Scholar]
- Matencio, A.; Navarro-Orcajada, S.; García-Carmona, F.; López-Nicolás, J.M. Applications of cyclodextrins in food science. A review. Trends Food Sci. Technol. 2020, 104, 132–143. [Google Scholar] [CrossRef]
- Martínez-Castañon, G.-A.; Nino-Martinez, N.; Martinez-Gutierrez, F.; Martinez-Mendoza, J.; Ruiz, F. Synthesis and antibacterial activity of silver nanoparticles with different sizes. J. Nanoparticle Res. 2008, 10, 1343–1348. [Google Scholar] [CrossRef]
- Yang, J.; Zhang, X.; Ma, Y.-H.; Gao, G.; Chen, X.; Jia, H.-R.; Li, Y.-H.; Chen, Z.; Wu, F.-G. Carbon dot-based platform for simultaneous bacterial distinguishment and antibacterial applications. ACS Appl. Mater. Interfaces 2016, 8, 32170–32181. [Google Scholar] [CrossRef]
- Rak, M.J.; Friščić, T.; Moores, A. One-step, solvent-free mechanosynthesis of silver nanoparticle-infused lignin composites for use as highly active multidrug resistant antibacterial filters. RSC Adv. 2016, 6, 58365–58370. [Google Scholar] [CrossRef] [Green Version]
- Desai, D.; Shende, P. Drug-free Cyclodextrin-based nanosponges for antimicrobial activity. J. Pharm. Innov. 2020, 16, 258–268. [Google Scholar] [CrossRef]
- Machelart, A.; Salzano, G.; Li, X.; Demars, A.; Debrie, A.-S.; Menendez-Miranda, M.; Pancani, E.; Jouny, S.; Hoffmann, E.; Deboosere, N. Intrinsic antibacterial activity of nanoparticles made of β-cyclodextrins potentiates their effect as drug nanocarriers against tuberculosis. ACS Nano 2019, 13, 3992–4007. [Google Scholar] [CrossRef]
- Liu, Y.; Jia, J.; Gao, T.; Wang, X.; Yu, J.; Wu, D.; Li, F. One-pot fabrication of antibacterial β-cyclodextrin-based nanoparticles and their superfast, broad-spectrum adsorption towards pollutants. J. Colloid Interface Sci. 2020, 576, 302–312. [Google Scholar]
- Khazaei Monfared, Y.; Mahmoudian, M.; Cecone, C.; Caldera, F.; Zakeri-Milani, P.; Matencio, A.; Trotta, F. Stabilization and Anticancer Enhancing Activity of the Peptide Nisin by Cyclodextrin-Based Nanosponges against Colon and Breast Cancer Cells. Polymers 2022, 14, 594. [Google Scholar] [CrossRef] [PubMed]
- Pawar, S.; Shende, P.; Trotta, F. Diversity of β-cyclodextrin-based nanosponges for transformation of actives. Int. J. Pharm. 2019, 565, 333–350. [Google Scholar] [CrossRef] [PubMed]
- Hoti, G.; Alberto, S.L.A.; Pedrazzo, R.; Cecone, C.; Matencio, A.; Trotta, F.; Caldera, F. Strategies to Develop Cyclodextrin-Based Nanosponges for Smart Drug Delivery; IntechOpen: London, UK, 2021. [Google Scholar]
- Dhakar, N.K.; Matencio, A.; Caldera, F.; Argenziano, M.; Cavalli, R.; Dianzani, C.; Zanetti, M.; López-Nicolás, J.M.; Trotta, F. Comparative evaluation of solubility, cytotoxicity and photostability studies of resveratrol and oxyresveratrol loaded nanosponges. Pharmaceutics 2019, 11, 545. [Google Scholar] [CrossRef] [PubMed] [Green Version]
- Shende, P.; Kulkarni, Y.A.; Gaud, R.; Deshmukh, K.; Cavalli, R.; Trotta, F.; Caldera, F. Acute and repeated dose toxicity studies of different β-cyclodextrin-based nanosponge formulations. J. Pharm. Sci. 2015, 104, 1856–1863. [Google Scholar] [CrossRef]
- Ibrahim, N.E.-S.; Morsy, H.; Abdelgwad, M. The Comparative Effect of Nisin and Thioridazine as Potential Anticancer Agents on Hepatocellular Carcinoma. Rep. Biochem. Mol. Biol. 2021, 9, 452. [Google Scholar] [CrossRef]
- Balouiri, M.; Sadiki, M.; Ibnsouda, S.K. Methods for in vitro evaluating antimicrobial activity: A review. J. Pharm. Anal. 2016, 6, 71–79. [Google Scholar] [CrossRef] [Green Version]
- van Vuuren, R.J.; Visagie, M.H.; Theron, A.E.; Joubert, A.M. Antimitotic drugs in the treatment of cancer. Cancer Chemother. Pharmacol. 2015, 76, 1101–1112. [Google Scholar] [CrossRef] [Green Version]
- Novikov, M.; Thong, K.L.; Zazali, N.I.M.; Abd Hamid, S.B. Treatment of cotton by β-cyclodextrin/triclosan inclusion complex and factors affecting antimicrobial properties. Fibers Polym. 2018, 19, 548–560. [Google Scholar] [CrossRef]
- Li, J.; Pan, D.; Yi, J.; Hao, L.; Kang, Q.; Liu, X.; Lu, L.; Lu, J. Protective effect of β-cyclodextrin on stability of nisin and corresponding interactions involved. Carbohydr. Polym. 2019, 223, 115115. [Google Scholar] [CrossRef]
- Appleton, S.L.; Tannous, M.; Argenziano, M.; Muntoni, E.; Rosa, A.C.; Rossi, D.; Caldera, F.; Scomparin, A.; Trotta, F.; Cavalli, R. Nanosponges as protein delivery systems: Insulin, a case study. Int. J. Pharm. 2020, 590, 119888. [Google Scholar] [CrossRef]
- Allahyari, S.; Esmailnezhad, N.; Valizadeh, H.; Ghorbani, M.; Jelvehgari, M.; Ghazi, F.; Zakeri-Milani, P. In-vitro characterization and cytotoxicity study of flutamide loaded cyclodextrin nanosponges. J. Drug Deliv. Sci. Technol. 2021, 61, 102275. [Google Scholar] [CrossRef]
- Alishahi, A. Antibacterial effect of chitosan nanoparticle loaded with nisin for the prolonged effect. J. Food Saf. 2014, 34, 111–118. [Google Scholar] [CrossRef]
- Delves-Broughton, J. Nisin and its application as a food preservative. J. Soc. Dairy Technol. 1990, 43, 73–76. [Google Scholar] [CrossRef]
- Niaz, T.; Shabbir, S.; Noor, T.; Abbasi, R.; Imran, M. Alginate-caseinate based pH-responsive nano-coacervates to combat resistant bacterial biofilms in oral cavity. Int. J. Biol. Macromol. 2020, 156, 1366–1380. [Google Scholar] [CrossRef]
- Delves-Broughton, J.; Blackburn, P.; Evans, R.J.; Hugenholtz, J. Applications of the bacteriocin, nisin. Antonie Van Leeuwenhoek 1996, 69, 193–202. [Google Scholar] [CrossRef]
- Gruskiene, R.; Kavleiskaja, T.; Staneviciene, R.; Kikionis, S.; Ioannou, E.; Serviene, E.; Roussis, V.; Sereikaite, J. Nisin-Loaded Ulvan Particles: Preparation and Characterization. Foods 2021, 10, 1007. [Google Scholar] [CrossRef]
- Hu, Y.; Wu, T.; Wu, C.; Fu, S.; Yuan, C.; Chen, S. Formation and optimization of chitosan-nisin microcapsules and its characterization for antibacterial activity. Food Control 2017, 72, 43–52. [Google Scholar] [CrossRef]
- Luo, L.; Wu, Y.; Liu, C.; Zou, Y.; Huang, L.; Liang, Y.; Ren, J.; Liu, Y.; Lin, Q. Elaboration and characterization of curcumin-loaded soy soluble polysaccharide (SSPS)-based nanocarriers mediated by antimicrobial peptide nisin. Food Chem. 2021, 336, 127669. [Google Scholar] [CrossRef]
- Wang, H.; She, Y.; Chu, C.; Liu, H.; Jiang, S.; Sun, M.; Jiang, S. Preparation, antimicrobial and release behaviors of nisin-poly (vinyl alcohol)/wheat gluten/ZrO2 nanofibrous membranes. J. Mater. Sci. 2015, 50, 5068–5078. [Google Scholar] [CrossRef]
- Wu, C.; Wu, T.; Fang, Z.; Zheng, J.; Xu, S.; Chen, S.; Hu, Y.; Ye, X. Formation, characterization and release kinetics of chitosan/γ-PGA encapsulated nisin nanoparticles. RSC Adv. 2016, 6, 46686–46695. [Google Scholar] [CrossRef]
- Arakha, M.; Borah, S.M.; Saleem, M.; Jha, A.N.; Jha, S. Interfacial assembly at silver nanoparticle enhances the antibacterial efficacy of nisin. Free Radic. Biol. Med. 2016, 101, 434–445. [Google Scholar] [CrossRef] [PubMed]
- Aachmann, F.L.; Aune, T.E.V. Use of cyclodextrin and its derivatives for increased transformation efficiency of competent bacterial cells. Appl. Microbiol. Biotechnol. 2009, 83, 589–596. [Google Scholar] [CrossRef] [PubMed]
- Bar, R.; Ulitzur, S. Bacterial toxicity of cyclodextrins: Luminuous Escherichia coli as a model. Appl. Microbiol. Biotechnol. 1994, 41, 574–577. [Google Scholar] [CrossRef] [PubMed]
- Piercey, M.; Mazzanti, G.; Budge, S.; Delaquis, P.; Paulson, A.; Hansen, L.T. Antimicrobial activity of cyclodextrin entrapped allyl isothiocyanate in a model system and packaged fresh-cut onions. Food Microbiol. 2012, 30, 213–218. [Google Scholar] [CrossRef]
- Rosa Teixeira, K.I.; Araújo, P.V.; Almeida Neves, B.R.; Bohorquez Mahecha, G.A.; Sinisterra, R.D.; Cortés, M.E. Ultrastructural changes in bacterial membranes induced by nano-assemblies β-cyclodextrin chlorhexidine: SEM, AFM, and TEM evaluation. Pharm. Dev. Technol. 2013, 18, 600–608. [Google Scholar] [CrossRef]
- Molnár, M.; Fenyvesi, É.; Berkl, Z.; Németh, I.; Fekete-Kertész, I.; Márton, R.; Vaszita, E.; Varga, E.; Ujj, D.; Szente, L. Cyclodextrin-mediated quorum quenching in the Aliivibrio fischeri bioluminescence model system–Modulation of bacterial communication. Int. J. Pharm. 2021, 594, 120150. [Google Scholar] [CrossRef]
- Deshmukh, K.; Tanwar, Y.S.; Sharma, S.; Shende, P.; Cavalli, R. Functionalized nanosponges for controlled antibacterial and antihypocalcemic actions. Biomed. Pharmacother. 2016, 84, 485–494. [Google Scholar] [CrossRef]
- Thiel, V.; Heim, C.; Arp, G.; Hahmann, U.; Sjövall, P.; Lausmaa, J. Biomarkers at the microscopic range: ToF-SIMS molecular imaging of Archaea-derived lipids in a microbial mat. Geobiology 2007, 5, 413–421. [Google Scholar] [CrossRef]
- Miao, J.; Peng, W.; Liu, G.; Chen, Y.; Chen, F.; Cao, Y. Biopreservative effect of the natural antimicrobial substance from Lactobacillus paracasei subsp. tolerans FX-6 on fresh pork during chilled storage. Food Control 2015, 56, 53–56. [Google Scholar] [CrossRef]
- Abril-Sánchez, C.; Matencio, A.; Navarro-Orcajada, S.; García-Carmona, F.; López-Nicolás, J.M. Evaluation of the properties of the essential oil citronellal nanoencapsulated by cyclodextrins. Chem. Phys. Lipids 2019, 219, 72–78. [Google Scholar] [CrossRef]
- Lavorgna, M.; Iacovino, R.; Russo, C.; Di Donato, C.; Piscitelli, C.; Isidori, M. A new approach for improving the antibacterial and tumor cytotoxic activities of pipemidic acid by including it in trimethyl-β-cyclodextrin. Int. J. Mol. Sci. 2019, 20, 416. [Google Scholar] [CrossRef] [Green Version]
- Wang, D.; Liang, J.; Wei, Z. Response of Deeply Buried Pipeline Laid through a Fault to Random Ground Motion. In International Efforts in Lifeline Earthquake Engineering; ASCE: Reston, VA, USA, 2014; pp. 176–183. [Google Scholar]
- Pan, D.; Zhang, D.; Hao, L.; Lin, S.; Kang, Q.; Liu, X.; Lu, L.; Lu, J. Protective effects of soybean protein and egg white protein on the antibacterial activity of nisin in the presence of trypsin. Food Chem. 2018, 239, 196–200. [Google Scholar] [CrossRef] [PubMed]
- Gruskiene, R.; Krivorotova, T.; Sereikaite, J. Nisin-loaded pectin and nisin-loaded pectin-inulin particles: Comparison of their proteolytic stability with free nisin. LWT-Food Sci. Technol. 2017, 82, 283–286. [Google Scholar] [CrossRef]
- Gedarawatte, S.T.; Ravensdale, J.T.; Al-Salami, H.; Dykes, G.A.; Coorey, R. Antimicrobial efficacy of nisin-loaded bacterial cellulose nanocrystals against selected meat spoilage lactic acid bacteria. Carbohydr. Polym. 2021, 251, 117096. [Google Scholar] [CrossRef] [PubMed]
- Wu, T.; Wu, C.; Fang, Z.; Ma, X.; Chen, S.; Hu, Y. Effect of chitosan microcapsules loaded with nisin on the preservation of small yellow croaker. Food Control 2017, 79, 317–324. [Google Scholar] [CrossRef]
- Lee, E.H.; Khan, I.; Oh, D.-H. Evaluation of the efficacy of nisin-loaded chitosan nanoparticles against foodborne pathogens in orange juice. J. Food Sci. Technol. 2018, 55, 1127–1133. [Google Scholar] [CrossRef] [PubMed]
- Chopra, M.; Kaur, P.; Bernela, M.; Thakur, R. Surfactant assisted nisin loaded chitosan-carageenan nanocapsule synthesis for controlling food pathogens. Food Control 2014, 37, 158–164. [Google Scholar] [CrossRef]

| MIC (µg/mL) | MBC (µg/mL) | |||||||
|---|---|---|---|---|---|---|---|---|
| Nisin | PMDA + Nisin | CDI + Nisin | β-CD + Nisin | Nisin | PMDA + Nisin | CDI + Nisin | β-CD + Nisin | |
| E. coli | ND | 625 | 625 | 1250 | ND | 1250 | 625 | 2500 |
| S. aureus | 5000 | 625 | 625 | 1250 | ND | 1250 | 625 | 2500 |
| MIC (µg/mL) | MBC (µg/mL) | |||||
|---|---|---|---|---|---|---|
| PMDA-NSs | CDI-NSs | β-CD | PMDA-NSs | CDI-NSs | β-CD | |
| E. coli | 10,000 | 5000 | 20,000 | 20,000 | 20,000 | ND |
| S. aureus | 20,000 | ND | ND | ND | ND | ND |
| TVC (log CFU/mL) | |||||
|---|---|---|---|---|---|
| Treatments | Storage Time (d) | ||||
| 0 | 3 | 7 | 14 | 30 | |
| C | 3.6 ± 0.04 | 4.8 ± 0.09 | 5.86 ± 0.05 | 7.05 ± 0.06 | 8.8 ± 0.03 |
| N | 3.08 ± 0.02 | 4.43 ± 0.04 | 5.28 ± 0.05 | 6.63 ± 0.04 | 8.5 ± 0.06 |
| N-P | 3.45± 0.05 | 4.72 ± 0.01 | 5.35 ± 0.04 | 6.85± 0.07 | 8.71 ± 0.01 |
| β-CD-N | 3.38 ± 0.03 | 4.30 ± 0.02 * | 5.17 ± 0.06 * | 6.57 ± 0.02 ns | 8.2 ± 0.07 * |
| β-CD-N-P | 3.55 ± 0.02 | 4.64 ± 0.03 # | 5.20 ± 0.02 # | 6.70 ± 0.05 # | 8.38 ± 0.06 # |
| CDI-N | 3.20 ± 0.06 | 3.9 ± 0.04 ** | 4.81 ± 0.04 *** | 5.54 ± 0.05 **** | 7.88 ± 0.04 *** |
| CDI-N-P | 3.34 ± 0.03 | 4.18 ± 0.04 ### | 4.94 ± 0.06 ## | 5.98 ± 0.03 ### | 8.07 ± 0.02 ### |
| PMDA-N | 3.24 ± 0.03 | 4.24 ± 0.05 * | 5.04 ± 0.05 ** | 6.33 ± 0.04 ** | 8.08 ± 0.05 ** |
| PMDA-N-P | 3.52 ± 0.05 | 4.45 ± 0.04 ## | 5.15 ± 0.03 # | 6.54 ± 0.06 ## | 8.25 ± 0.05 ## |
Publisher’s Note: MDPI stays neutral with regard to jurisdictional claims in published maps and institutional affiliations. |
© 2022 by the authors. Licensee MDPI, Basel, Switzerland. This article is an open access article distributed under the terms and conditions of the Creative Commons Attribution (CC BY) license (https://creativecommons.org/licenses/by/4.0/).
Share and Cite
Khazaei Monfared, Y.; Mahmoudian, M.; Hoti, G.; Caldera, F.; López Nicolás, J.M.; Zakeri-Milani, P.; Matencio, A.; Trotta, F. Cyclodextrin-Based Nanosponges as Perse Antimicrobial Agents Increase the Activity of Natural Antimicrobial Peptide Nisin. Pharmaceutics 2022, 14, 685. https://doi.org/10.3390/pharmaceutics14030685
Khazaei Monfared Y, Mahmoudian M, Hoti G, Caldera F, López Nicolás JM, Zakeri-Milani P, Matencio A, Trotta F. Cyclodextrin-Based Nanosponges as Perse Antimicrobial Agents Increase the Activity of Natural Antimicrobial Peptide Nisin. Pharmaceutics. 2022; 14(3):685. https://doi.org/10.3390/pharmaceutics14030685
Chicago/Turabian StyleKhazaei Monfared, Yousef, Mohammad Mahmoudian, Gjylije Hoti, Fabrizio Caldera, José Manuel López Nicolás, Parvin Zakeri-Milani, Adrián Matencio, and Francesco Trotta. 2022. "Cyclodextrin-Based Nanosponges as Perse Antimicrobial Agents Increase the Activity of Natural Antimicrobial Peptide Nisin" Pharmaceutics 14, no. 3: 685. https://doi.org/10.3390/pharmaceutics14030685
APA StyleKhazaei Monfared, Y., Mahmoudian, M., Hoti, G., Caldera, F., López Nicolás, J. M., Zakeri-Milani, P., Matencio, A., & Trotta, F. (2022). Cyclodextrin-Based Nanosponges as Perse Antimicrobial Agents Increase the Activity of Natural Antimicrobial Peptide Nisin. Pharmaceutics, 14(3), 685. https://doi.org/10.3390/pharmaceutics14030685

